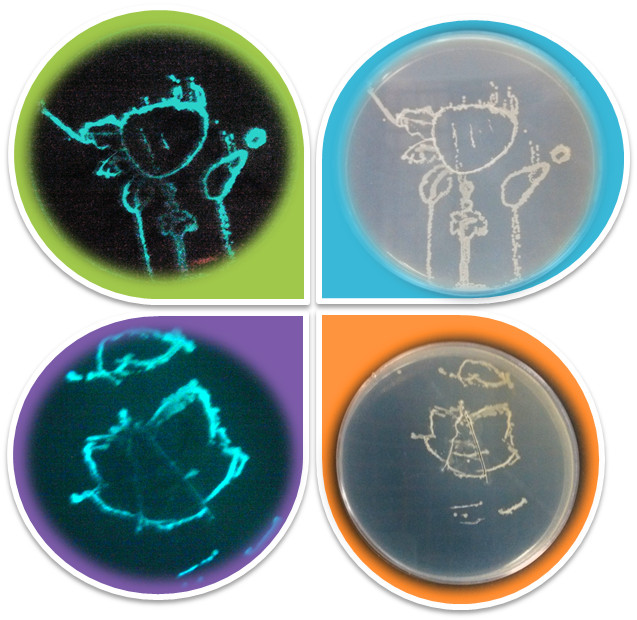

新聞聚焦
“零距離”親近神秘的生物世界
---生物院首屆公眾科學日活動側記
5月19日突然來襲的暴雨並沒擋住廣州碧桂園(IB國際)學校小學部四、五年級師生們外出參觀學習的腳步,這是為什麼呢?原來,中科院廣州生物醫藥與健康研究院在當天舉辦“公眾科學日”,生物院老師們將活動的內容做成精美的活頁冊,提前向他們做了預告。
孩子們興高采烈地來到生物院,聽取了生物院的整體情況介紹,參觀了生物院公用儀器中心先進的科研儀器裝備。隨後,根據各自的興趣愛好,孩子們分成幹細胞組、克隆組、寄生蟲組、微生物組、化學組進入相關研究室開展實驗互動。實驗服都還沒有穿好,孩子們就迫不急待地發問:克隆是什麼樣的?怎樣才能像孫悟空和豬八戒一樣能進行36變和72變?為什麼IRC小鼠的毛是白色的?怎樣轉基因?轉基因食物安全嗎?怎樣防治禽流感?熒光粉和熒光蛋白有區別嗎?沾了含有寄生蟲的水之後會不會從皮膚感染寄生蟲?一籮筐的問題讓科普誌願者都快招架不住了。
實驗室裏,生物院的科研成果更是深深地吸引著孩子們的目光,他們的困惑更多來自對生命現象的好奇和親身體驗科學研究的衝動。各科研團隊根據研究方向設計的從宏觀到微觀的各類科學小實驗都讓孩子們充滿興趣。在科普誌願者的帶領下,孩子們十分投入,他們在幹細胞組從細胞、組織、器官、個體四個層麵觀察了多種幹細胞及幹細胞衍生的一係列功能細胞,並親自動手操作了細胞換液培養等過程;在克隆組,孩子們學習了如何使用移液器,看到了如何給小鼠做手術,如何將基因注入到小鼠的輸精管中等實驗;寄生蟲組的實驗室裏,孩子們觀看了染色血塗片的製作過程,觀察到紅細胞中的瘧原蟲,還了解到寄生成蟲從幼蟲到成蟲的變化;微生物組的孩子們看到暗室中發綠光的微生物平板圖案,並親自在平板中繪上了自己的名字和喜歡的圖案;化學組的老師們則通過1+1≠2、鐵樹開花、色彩的奧秘、大象牙膏等有趣的小遊戲向孩子們普及了分子的間隙與擴散、置換反應、有色物質的生成、雙氧水的分解等化學知識,更讓孩子們製作了專屬於自己的有機分子球棒模型,普及了有機分子空間結構的相關知識。
在科學的海洋中遊玩,孩子們大呼過癮,忙得不亦樂乎。一位姓楊的同學告訴工作人員:“他走進實驗室後覺得這微觀世界突然變大了,變得那麼精彩紛呈而不是想象中那麼的枯燥”。孩子們還紛紛抓住了這次難得的與科學家麵對麵的機會,向科學家們提出自己感興趣的問題,並得到了通俗、細致的回答。活動在一陣陣的驚歎聲、感慨聲、歡呼雀躍聲、各種問不完的問題以及同學們的依依不舍中順利結束。
“孩子們對科學很崇尚,應該讓他們多接觸科學,保持這種崇尚。就是要他們親眼看看科學研究是怎麼回事,科學家都是什麼人,打破他們對科學的神秘感。此次活動孩子們不僅獲得了最新最前沿的科普知識,還可以與科學家、科研成果“親密接觸”,在互動中真切感受科技圓夢的力量”。碧桂園學校帶隊來參觀的老師在上車前對生物院科普誌願者們充滿感謝。
其實科學普及工作一直是生物院工作的重點。科學研究本身不是最終的目的,生物院更希望能夠通過各種方式的普及,讓人們去掌握它、了解它,讓科學能夠惠及民眾的生活和健康。未來生物院也將通過更多的形式將生物院重要研究成果向社會普及,讓更多公眾零距離接觸生命科學。本次公眾科學日共進行了3天(5月18-20日),在此期間,共有廣州企事業單位、中小學生、社會民眾等100多人參與。除了上述的中小學生科普活動外,生物院還安排了麵向大學生、研究生以及家長的研究生教育谘詢活動和麵向企事業單位的動物實驗技術培訓活動,向社會宣傳了生物院近年來的教育成效和師資隊伍以及支撐中心可提供服務的項目等內容。廣州冠昊科技園、中山大學水生經濟動物研究所等公司及研究單位均表示了進一步合作的興趣。

孩子們觀看生物院科研成果介紹

孩子們的實驗成果:喜羊羊和小灰灰的暗室照片和正常光照片

孩子們的實驗成果:大象牙膏

孩子們的實驗成果:製作了專屬於自己的有機分子球棒模型

孩子們的小禮物:GIBH科普活頁冊

麵向社會公眾的研究生教育谘詢和動物實驗培訓活動

活動合影
